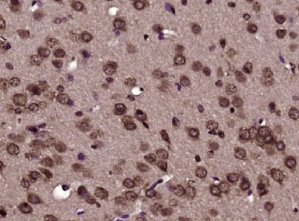

英文名称:Anti-Bcl-xL
中文名称:Bcl-xL蛋白抗体
抗体来源:兔子
克隆类型:多克隆
交叉反应:人、小鼠、大鼠、狗、猪、马、羊
产品应用:WB=1:500-2000 ELISA=1:500-1000 IHC-P=1:100-500 IHC-F=1:100-500 Flow-Cyt=1ug/Test ICC=1:100-500 IF=1:100-500(石蜡切片需做抗原修复)
分 子 量:26kDa
细胞定位:细胞核 细胞浆 细胞膜 线粒体
状态:冻干或液体
浓度:1mg/ml
来源于:KLH conjugated synthetic peptide derived from human Bcl-xL:81-200/233
亚型:IgG
纯化方法:affinity purified by Protein A
储存液:0.01M TBS(pH7.4) with 1% BSA, 0.03% Proclin300 and 50% Glycerol.
别 名:Apoptosis regulator Bcl X; BclX; Bcl-X; Bcl 2 like 1; Bcl 2 like 1 protein; Bcl xL; BCL X/L; BCL XL/S; Bcl xS; Bcl2 like1; BCL2-related gene; BCL2-related protein, long isoform, included; BCLXL, included; BCL2-related protein, short isoform, included; BCLXS, included; BCL2L; Bclx; DKFZp781P2092; MGC113803; MGC99998; B2CL1_HUMAN.
保存条件:在-20°C下保存一年。避免反复冻融。冻干抗体在室温下至少稳定一个月,并在-20°C下保持一年以上。当在无菌pH7.4 0.01M PBS或抗体稀释剂中重组时,抗体在2-4°C下至少稳定两周。
产品介绍:
该基因编码的蛋白属于bcl-2蛋白家族。bcl-2家族成员形成异二聚体或同二聚体,并充当参与多种细胞活动的抗或促凋亡调节器。该基因编码的蛋白质位于线粒体外膜,并已被证明调节线粒体外膜通道(VDAC)的开放。VDAC调节线粒体膜电位,从而控制活性氧的产生和线粒体释放细胞色素C,这两种物质都是细胞凋亡的有效诱导物。两个选择性剪接转录变体,编码不同的亚型,已被报道。较长的亚型作为凋亡抑制剂,较短的亚型作为凋亡激活剂。[由RefSeq提供,2008年7月]。
功能:
有效的细胞死亡抑制剂。抑制半胱天冬酶的激活(通过相似性)。似乎通过阻断与之结合的电压依赖性阴离子通道(vdac)并阻止caspase激活剂cyc1从线粒体膜释放来调节细胞死亡。在有丝分裂过程中,还充当G2检查点和细胞因子增多的调节器。
亚型bcl-x(s)促进细胞凋亡。
子单元:
同二聚体。亚型bcl-x(l)与bax、bak或bcl2形成异二聚体。BAX的异二聚化似乎不需要抗凋亡活性。与BCL2L11相互作用。与DMN1L相互作用,刺激突触中DMN1L的GTP酶活性,增加轴突线粒体数量和突触囊泡簇的大小和数目。与BAD和BBC3交互。与siva1(亚型1)相互作用(bcl-x(l));这种相互作用抑制抗凋亡活性。与BECN1和PGAM5相互作用。与bax(异形sigma)相互作用(异形bcl-x(l))。亚型bcl-x(l)与ikzf3相互作用。与HEBP2交互。
亚细胞位置:
线粒体膜;单通道膜蛋白。核膜;单通道膜蛋白;胞质侧。细胞质,细胞骨架,中心体。注=线粒体膜和核周膜。当在ser-49磷酸化时定位到中心体。
组织特异性:
Bcl-x(s)在经历高转化率的细胞中高水平表达,如淋巴细胞的形成。相比之下,bcl-x(l)存在于含有长寿后细胞的组织中,如成人大脑。
翻译后修改:
细胞凋亡过程中被半胱天冬酶蛋白分解。分裂蛋白缺乏bh4基序,具有促凋亡活性。
通过cdk1磷酸化在ser-62上。这种磷酸化在正常有丝分裂细胞中是部分的,但在G2细胞中在DNA损伤后*被抑制,因此可能通过触发半胱天冬酶介导的蛋白水解来促进随后的细胞凋亡。PLK3磷酸化,导致调节G2检查点,并在有丝分裂过程中进展为细胞因子。SER-49的磷酸化出现在S期和G2期,在有丝分裂早期、中期和后期迅速消失,在末期和细胞分裂中再次出现。
相似性:
属于BCL-2家族。
重要提示:
本产品仅用于研究用途,不用于人类、治疗或诊断应用
Bcl X/L蛋白是Bcl蛋白家族的成员之一,是细胞中抑制细胞凋亡的重要分子之一,Bcl-X/L是结构上与Bcl-2具有43%同源性的蛋白,与Bcl-2的作用相同,可抑制细胞凋亡,在肿瘤的发生和发展中起重要作用。
多聚甲醛固定,石蜡包埋(小鼠脑组织);用柠檬酸钠缓冲液(pH6.0)煮沸15min后提取抗原;用3%过氧化氢阻断内源过氧化物酶20分钟;阻断缓冲液(正常山羊血清)37℃30min;用Bcl-xL聚合酶进行抗体孵育克隆抗体,未结合,1:400,4℃过夜,然后根据SP试剂盒(兔子)说明和DAB染色进行操作。
公司优势:
1)质量:我司提供的的试剂为世界。
2)价格:价格实惠,量大从优。
4)服务:提供完整的售前、售后和售中服务。售后到底。
如需订购Bcl-xL蛋白抗体,请联系我们。
| Anti-DPPA2 (developmental pluripotency associated gene2) 多能发育相关基因2抗体 |
| Anti-DR3/TNF-αR/TRAMP (death receptor 3) TNF-α膜受体抗体/DR3 死亡受体3抗体 |
| Anti-DR4/APO2/TRAILR1 (Death receptor 4) 死亡受体4抗体 |
| Anti-DTNBP1 (Dysbindin-1) 精神分裂症易感基因抗体 |
| Anti-DVL1 (dishevelled 1) 蓬乱蛋白1抗体 |
| Anti-Dynamin 2(Mouse Anti-Human Dynamin-2 Monoclonal Antibody) 鼠抗人鸟苷三磷酸酶-发动蛋白2单克隆抗体 |